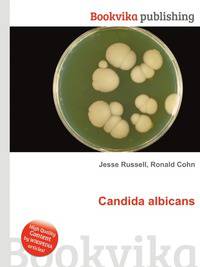
Candida albicans

Поиск книг, учебников, пособий в онлайн-магазинах
Candida albicans
Автор: Jesse Russell,Ronald Cohn, 114 стр., издатель: "Книга по Требованию", ISBN: 978-5-5117-7293-6High Quality Content by WIKIPEDIA articles! Candida albicans is a diploid fungus that grows both as yeast and filamentous cells and a causal agent of opportunistic oral and genital infections in humans. Systemic fungal infections (fungemias) including those by C. albicans have emerged as important causes of morbidity and mortality in immunocompromised patients (e.g., AIDS, cancer chemotherapy, organ or bone marrow transplantation). C. albicans biofilms may form on the surface of implantable medical devices. In addition, hospital-acquired infections by C. albicans have become a cause of major health concerns. Данное издание представляет собой компиляцию сведений, находящихся в свободном доступе в среде Интернет в целом, и в информационном сетевом ресурсе "Википедия" в частности. Собранная по частотным запросам указанной тематики, данная компиляция построена по принципу подбора близких информационных ссылок, не имеет самостоятельного сюжета, не содержит никаких аналитических материалов,...
| В наличии: | ||||
|
|
Sprinter - 1124 руб. |
Перейти 
|
 Лучшая цена Лучшая цена
|
|
|
|
Books.Ru - 1258 руб. |
Перейти 
|
||
| Под заказ: | ||||
|
|
OZON.ru - 1254 руб. |
Перейти 
|
||
Рейтинг книги: 



 5 из 5, 8 голос(-ов).
5 из 5, 8 голос(-ов).




 5 из 5, 8 голос(-ов).
5 из 5, 8 голос(-ов).



